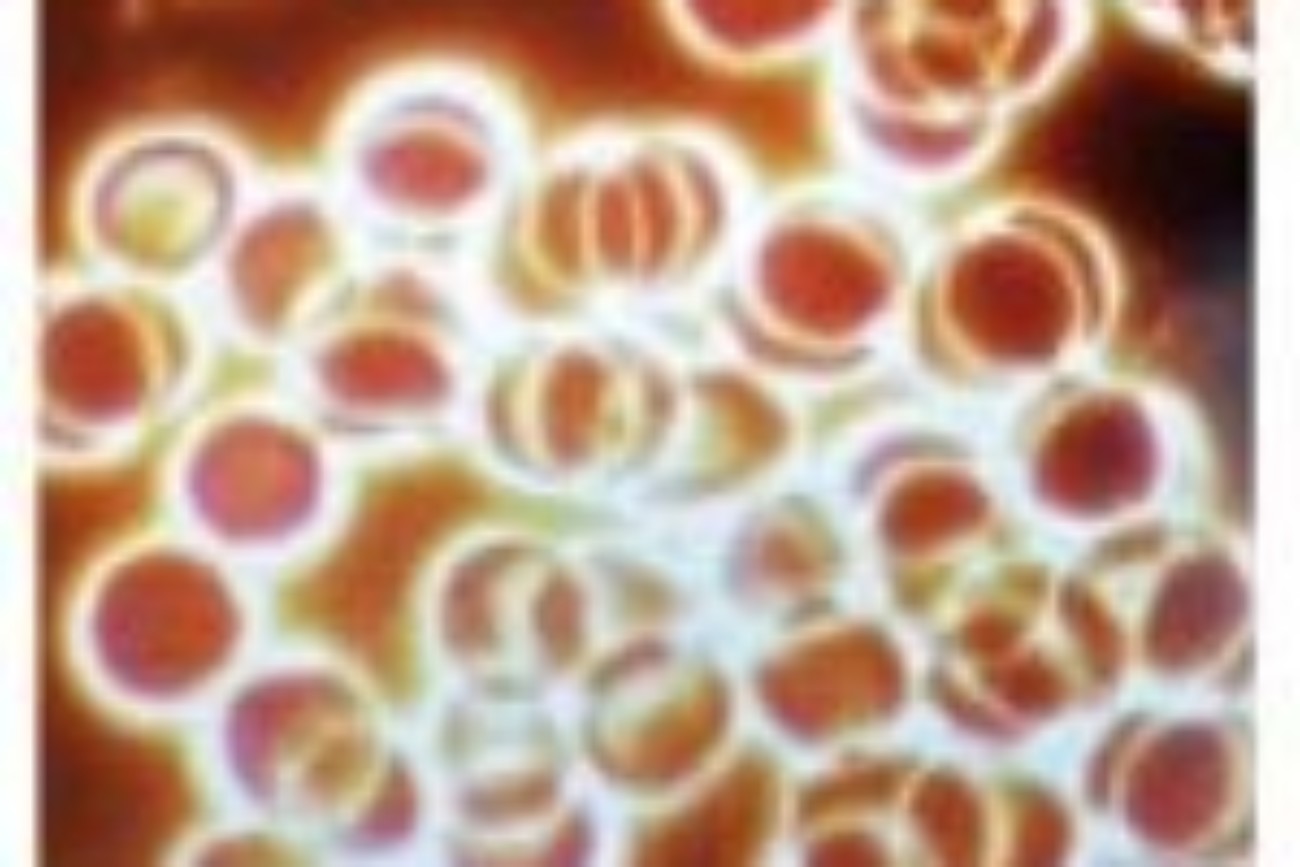
1
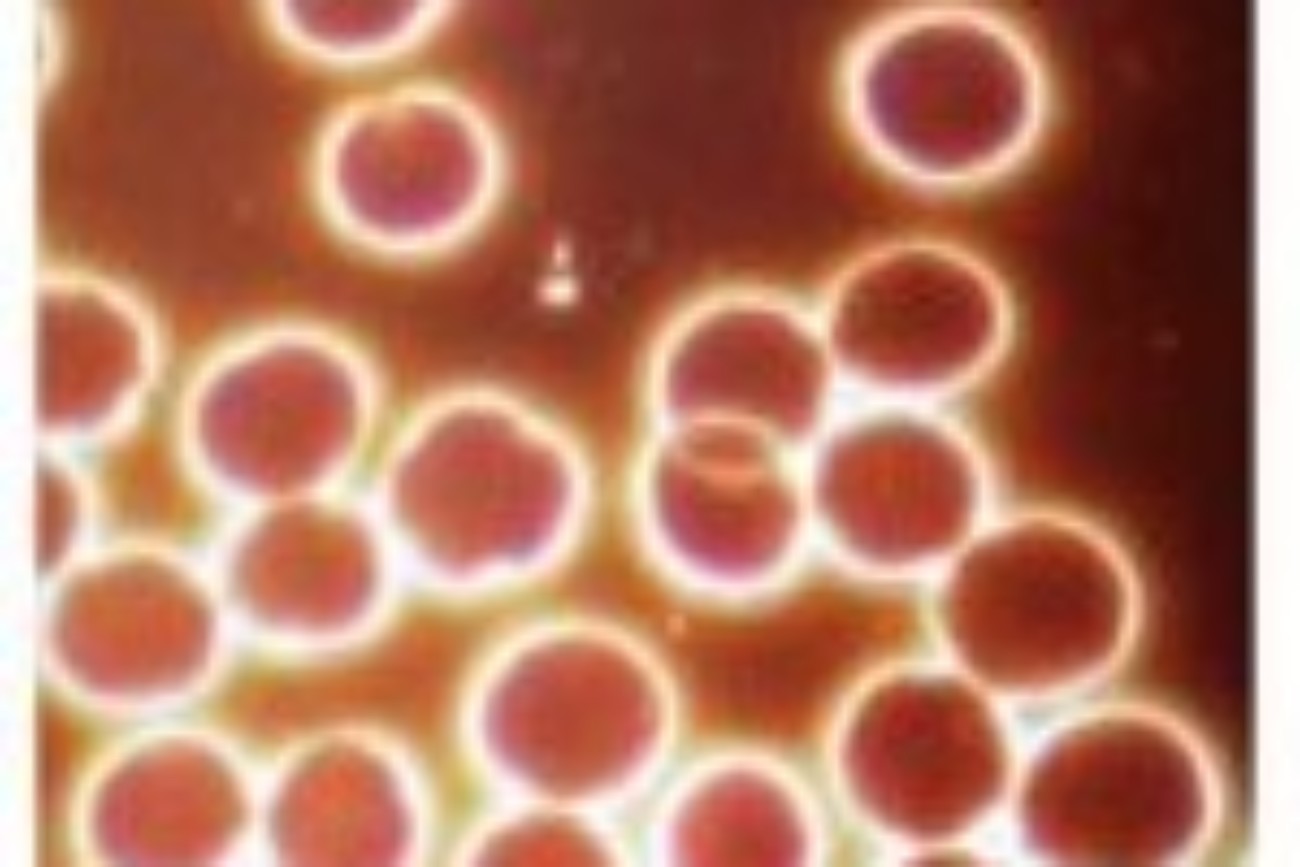
3

"La musique est peut-être l’exemple unique de ce qu’aurait pu être (s’il n’y avait pas eu l’invention du langage, la formation des mots, l’analyse des idées), la communication des âmes."
Renforcer les liens humains
Au cœur de tous les projets du Labodidées existe une intention de développer des supports qui élèvent nos vibrations. L’accès à des solutions qui nous aident à élever la conscience dans un monde en plein changement en étant certain que chacun trouve sa place, ce qu’il attend, et même plus : « Un parfum parce qu’il nous protège ou qu’il ouvre notre esprit, une oeuvre d’art qui nous transcende, nous connecte au beau et nous aide à changer de plan de conscience, une architecture ou il fait bon vivre et s’épanouir, se ressourcer, une alimentation éthique et bonne pour la santé du corps et de l’esprit, une cosmétique qui nous sublime et génère de la beauté intégrale, une musique qui nous aide à nous transformer, améliorer notre performance, méditer, dynamiser notre vie ».
Ce travail commence dès aujourd’hui avec le développement de Playlists élaborées à partir des créations musicales de BioMusic One.
Playlist n° 1 : L’équilibre du Nombre d’Or
Comment la Playlist est-elle créée?
Grâce à des mesures sensorielles, intuitives et liées à l’intelligence du coeur et la pulsologie, nous avons identifié les effets vibratoires en terme d’information des 63 titres de l’ensemble des albums de Bio music One. Nous avons sélectionné 13 morceaux dans un ordre précis pour créer une première Playlist, une séquence source qui s’accorde aux visions développés par la méthode développée par Christian Roche depuis plus de 30 ans.
Cette Playlist (13 titres, plus d’1heure et 21 mn. d’écoute) est créée comme une architecture sonore issue des propriétés du Nombre d’Or. Une géométrie fréquentielle qui dynamise la trame de votre conscience, accompagne votre harmonie, votre expansion et votre rayonnement.
"Si vous voulez trouver les secrets de l’univers, pensez en termes d’énergie, de fréquence, d’information et de vibration"
Les vibrations sonores bénéfiques des Playlist BioMusic One vous aident à initier des changements positifs dans votre vie…
- 1. Retrouver vos capacités vitales,
- 2. Manifester pleinement vos potentiels,
- 3. Exprimer mieux votre identité.
Comment télécharger la Playlist sur son ordinateur, sa tablette, son téléphone?
Vous pouvez vous rendre sur la boutique du Labodidées
et cliquer sur les liens
Vous pouvez également aller directement sur la boutique du site BioMusic One
Créez un compte sur cette boutique afin d’effectuer vos achats. Un code de réduction de 5 % – oem1 – a été négocié par le Labodidées.
Vous pouvez également Télécharger les Playlists Christian Roche plays BioMusicOne
Une fois vos achats effectués, vous trouverez le lien de téléchargement de la playlist sur votre ordinateur, tablette, téléphone et dans la confirmation de commande par email qui apparaitra suite à sa validation. Si vous ne téléchargez pas votre playlist avant de fermer la page, vous la trouverez également en cliquant sur l’onglet «Téléchargements » sur le menu de votre espace client.e. Vous avez droit à deux téléchargements pour utiliser votre playlist sur deux appareils à la fois (par exemple : smartphone + ordinateur) ou bien pour en garder un en réserve, au cas où. Lorsque vous aurez téléchargé votre playlist deux fois, vous ne verrez plus le téléchargement disponible dans votre espace client.
Les Playlists existent également sous forme de clé USB et le 1ère Playlist est disponible ici : Playlist du Nombre d’Or
Par une utilisation régulière en Modes Inaudible et Continu ou en Ecoute Consciente, la séquence source Playlist du Nombre d’Or vous aide sur tous les plans de votre être.
C’est un voyage sensuel, sensitif, sensoriel et initiatique de 13 titres Bio Music One, qui nous amène dans un premier temps à toucher le cœur de tous les systèmes qui nous structurent : terre, corps, ADN, cœur, (architecture vivante) pour ensuite faire évoluer notre conscience globale vers l’expansion, mettre en vibration l’être et lui permettre de rayonner.”
NOMBREUSES VALIDATIONS
L’ amélioration du Golden Ratio des hématies a été démontré par des tests effectués sur le sang humain au moyen du microscope à fond noir, réalisés par le Dr Domingo Pérez León, Directeur de l’Institut Biologique de la Santé de Madrid et par Pam Layfield, chercheuse en Microscopie Nutritionnelle.
- 1) Prise de sang avant exposition aux ondes d’un téléphone portable.
- 2) Prise de sang du même patient pendant qu’il est soumis au champ électromagnétique de son téléphone portable : on observe que les globules rouges présentent une disposition en forme d’effet rouleau, indicatif d’une perte de Golden Ratio et à la source d’un manque d’oxygénation avec des conséquences sur l’ensemble du corps, des cellules et des organes.
- 3) Prise de sang du même patient toujours exposé tout en étant soumis aux fréquences de Bio Music One pendant une heure. On observe que les globules rouges se séparent, signe d’une récupération de leur Golden Ratio, de l’amélioration de l’oxygénation du sang et de la neutralisation de la perturbation du champ électromagnétique produit par le téléphone portable.
Sur l’image à gauche, on voit en haut la courbe d’enregistrement de la variabilité du coeur d’une personne qui respire en rythme respiratoire 5 sec de temps d’inspire et 5 sec de temps d’expire permettant de se mettre en cohérence cardiaque. Le Power Spectrum, pics 1 et 2 montre une difficulté à se mettre en cohérence cardiaque avec une fonction plus intense du système sympathique zone VLF (1) et un pic étendu et décentré de la zone du bien-être LF (2)
Avec écoute de la Playlist:
Lors d’un deuxième enregistrement avec même respiration 5sec/5sec, le Power Spectrum montre une régulation du système sympathique zone VLF ( 1) et un pic centré sur la zone du bien-être LF (2).
Ceci indique un effet puissant d’amélioration de l’équilibre neuro végétatif, de la balance sympato-vagale grâce à l’écoute de BioMusic One.